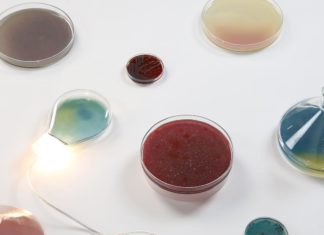

Take Comfort In Meghan Shimek’s Woven Wall Hangings
There's something undeniably comfy about textile art, especially when it comes in the form of an intricate wall hanging. Meghan Shimek's large scale woven wall hangings reveal the beauty and comfort that lies within....
Find Comfort in Lorena Marañon’s Quilts
Lorena Marañon's creative process requires intuition as much as it requires planning - and sometimes, even more. Known for her colorful quilts, each piece is imbued with spontaneity, with one step dictating the...
Eda Atay Pastirmaci’s Handbags Are Truly Original
Call us hoarders, but when it comes to handbags there's no such thing as owning too much. This is especially true in the case of handcrafted bags made with love and precision. Enter Eda...
This Series Will Encourage You to Read
In times when traveling is forbidden, there is a certain form of travel that is still permissible, encouraged even. We're talking, of course, about the power reading has to transport you to a different...
Dmitry Reutov Will Inspire You to Add Some Color to Your Home
Now, more than ever, is time to rethink our interior design. A beautiful home, after all, means a more pleasant experience overall, and how we divide our space may actually affect how we perceive...
You Won’t Believe What These Lamps Are Made Of
What happens when you add ingenuity and biology to industrial design? Jan Klingler's custom lamps could be one possible answer. Made to resemble Petri dishes and test tubes, his lamps showcase samples...
Couple Makes Hand-Crafted Jewelry Inspired By Video Games
Maxim and Diana of Maple Fox Wood is a Russian artistic duo who creates unique jewelry pieces inspired by video games including Warhammer, Dota 2, and The Witcher 3. To create their pendants, rings,...
Kasia’s Digital Portraits Are Cool and Collected
Bold, brash, and most often than not, pink, Kasia's digital illustrations have a fashionable air to them. Describing her creative style as “obsessive perfectionism,” her work mostly consists of portraits, with her characters looking...
These Lamps Blend Nicely Into Their Natural Surrounding
Jean-Luc Godard has a way around wood and metal. With a background in furniture design and custom sign making, Godard is keen on working with raw materials, from which he forms distinct, naturalistic sculptures...
Karrie Dean’s Blankets are Colorful, Textured, and Comforting
Interior design doesn't always have to be about breaking your walls and breaking the bank. Sometimes, it's the smallest details that make a difference: a unique lamp, an original coat hanger, or in Karrie...